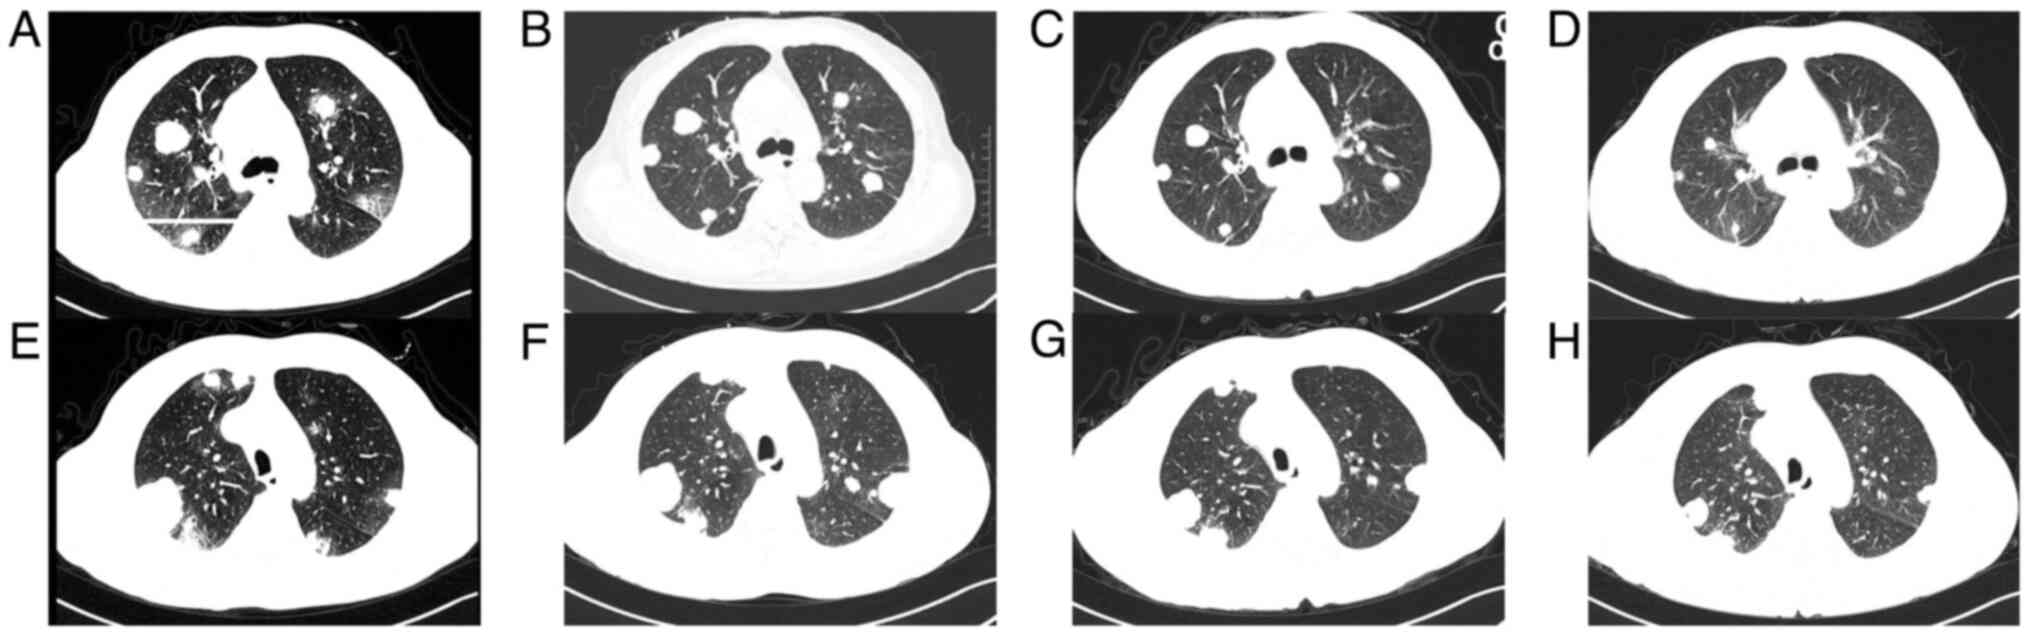

Introduction
Testicular cancer (TC) is a rare disease, accounting
for only ~1% of all male neoplasms, and 3.5% of male genital system
tumours (1). The incidence of TC
has steadily risen in recent years, resulting in an increase in
mortality (1). Germ cell tumours
(GCTs) account for ~95% of TC, including seminomas and
non-seminomatous germ cell tumours (NSGCTs). NSGCTs consist of
diverse histological subtypes including embryonal carcinoma, yolk
sac carcinoma, teratoma, choriocarcinoma (CC) and mixed testicular
CC (2,3). Of all NSGCTs, testicular CC is the
rarest subtype and is characterized as highly aggressive with early
haematogenous metastasis to the lungs, liver, brain and other
organs (4). As CC is usually
detected as a component of mixed testicular GCTs, pure CC is
extremely rare in TC (0.2-0.6%) (5,6).
As a unique malignancy consisting of mononuclear
cytotrophoblasts (cytotrophoblasts, intermediate trophoblasts) and
multinucleated syncytiotrophobalsts, CC can commonly arise in three
potential scenarios that are characterized by the production of
human chorionic gonadotrophin (HCG). These scenarios include: i)
Gestational CC occurring within or outside of the uterus followed
by pregnancy; ii) non-gestational CC originating from germ cells in
the gonads or midline locations outside of the gonads (such as the
mediastinum, retroperitoneum, and pineal gland) (7); and iii) infrequently, non-gestational
CC primarily presenting in parenchymal organs, such as the lungs
and gastrointestinal tract (8,9).
In cases of testicular CC, tumours originate from
germ cells in the testicular gonads of males with abnormally high
levels of HCG. It predominantly affects children and young adults,
accompanied by varying proportions of seminoma, embryonal
carcinoma, yolk sac tumour, and teratoma (4). Hence, pure testicular CC is extremely
rare and distinguished by unique clinical features which set it
apart from other types of NSGCTs. As established, CC tends to
rapidly proliferate and invade, and is prone to vascularity that
leads to subsequent necrosis (10). Although CC is rare in males, the
tendency for haemorrhaging persists in a similar way to female
patients. Furthermore, patients with CC often experience early
metastases, with hematogenous spread to organs beyond regional
lymph nodes, such as the lungs, liver, and brain (11). All of these factors contribute to a
poorer prognosis of testicular CC in comparison with other types of
TCs (2).
Therefore, although TC in general is highly curable,
treating testicular CC, a unique type of testicular NSGCT, can be
challenging. Radical orchiectomy should be performed promptly after
clinical diagnosis, for the purpose of proper diagnosis and primary
tumour control. Subsequently, chemotherapy plays a crucial role in
cases at either early or advanced stages (12). However, treatment options for
refractory or relapse cases are limited. Alternative chemotherapy
protocols and high-dose chemotherapy (HDCT) with autologous stem
cell transplantation (ASCT) should be considered in such
circumstances. Nevertheless, new agents targeting these patients
have yet to be extensively explored (13).
In the present study, a case of pure testicular CC
of a male patient aged 65 years with lung and brain metastases is
reported. The patient survived for 8 months after chemotherapy and
radiotherapy, but eventually succumbed due to failure of
maintenance of chemotherapy. Considering the severe side effects of
chemotherapy, promising targeted therapies that have shown
potential benefit in prolonging the survival of patients with GCTs
are summarized. All of these new targeted therapies offer new
approaches to maintenance therapy for patients with advanced GCTs,
with fewer side effects.
Case report
A 65-year-old male patient from Tibet was referred
to Hospital of Chengdu Office of People's Government of Tibetan
Autonomous Region (Chengdu, China), on 11 September 2021, for
cough, haemoptysis and thoracic back pain experienced in the
previous four weeks. The patient also complained of an enlarging
right testicular mass detected in the previous two weeks. The
patient denied any history of fever, abdominal pain, headache and
vomiting and had no relevant medical or surgical history.
Upon physical examination, the patient was conscious
and vitally stable. Diffuse enlargement of the right testicle was
observed, which was firm and tender to palpation. The left testicle
was normal.
Basic laboratory evaluation revealed severe anaemia
with a haemoglobin concentration of 5.8 g/dl. Initial laboratory
results of the tumour markers showed high HCG (35,586 mIU/ml;
normal range, <2 mIU/ml), lactate dehydrogenase (LDH) was
elevated to 339 U/l (normal range, 125-250 U/l), and
alpha-fetoprotein (AFP) was <2.5 ng/ml.
Magnetic resonance imaging (MRI) of the pelvis
showed a right scrotal mass with malignant features (6x4.8x3.4 cm)
(Fig. 1A and B). A computed tomography (CT) scan of the
chest revealed multiple metastases to the bilateral lungs. A brain
MRI was then performed for further evaluation and showed no
malignant lesions in the brain.
After 4 units of red blood cell transfusion, the
patient underwent orchiectomy and the specimen underwent
pathological examination. Removed tumour tissue was immediately
fixed with 4% neutral formalin for histopathological diagnosis and
immunohistochemical (IHC) staining for 24 h. After being dehydrated
through alcohol, the samples were embedded by paraffin.
For the microscopic histochemical analysis, 4-µm
slices were cut from the paraffin blocks, deparaffinized in xylene
and hydrated through the application of a series of alcohol.
Sections were stained with haematoxylin (3%; 2 min) and eosin
(0.5%; 1 min), and then the sections were observed by two
independent pathologists under a light microscope (BX43; Olympus
Corporation).
For the IHC analysis, serial 4-µm sections obtained
from the paraffin block were stained for HCG, pan-cytokeratin
(pan-CK), Ki67, AFP, vimentin (Vim), CD117, OCT3/4 and CD30.
Sections were incubated overnight at 4˚C with the primary
antibodies including: Rabbit anti-human HCG antibody (cat. no.
ZA-0703; ZSGB-BIO), mouse anti-human CK (pan) antibody (cat. no.
ZM-0069; ZSGB-BIO), rabbit anti-human Ki-67 antibody (cat. no.
RMA-0731; MXB), mouse anti-human AFP antibody (cat. no. ZM-0009;
ZSGB-BIO), rabbit anti-human Vim antibody (cat. no. ZA-0511;
ZSGB-BIO), rabbit anti-human CD117 antibody (cat. no. ZA-0523;
ZSGB-BIO), mouse anti-human OCT3/4 antibody (cat. no. MAB-0874,
MXB), and mouse anti-human CD30 antibody (cat. no. MAB-0868; MXB).
Subsequently, the slides were washed and incubated with a
horseradish peroxidase-conjugated secondary antibody (cat. no.
PV-6000; ZSGB-BIO) at 37˚C for 20 min. The immunostaining was
carried out with 3,3'-diaminobenzidine chromogen (DAB), and
counterstaining with hematoxylin for 5 min at 25˚C. Positive
expression of cells was observed by two independent pathologists
under a light microscope (BX43; Olympus Corporation).
Microscopic histopathology confirmed the diagnosis
of pure testicular CC. It showed extensive parenchymal replacement
by a biphasic pattern of syncytiotrophoblasts and cytotrophoblasts
with haemorrhage and necrosis (Fig.
2A-D). Microscopically, haemorrhage and necrosis were observed
in association with the tumour (Fig.
2A); and tumour cells were composed of syncytiotrophoblast and
cytotrophoblast cells (Fig. 2B).
Multinucleated syncytiotrophoblast cells were with sizeable and
irregular nuclei (Fig. 2C), and
demonstrated strong IHC staining of HCG (Fig. 2D).
 | Figure 2Histopathology images with typical
microscopic appearance of choriocarcinoma. (A) H&E staining,
revealing extensive areas of haemorrhage and necrosis associated
with the tumour; magnification, x40 and scale bar, 200 µm. (B) A
higher power image of the tumour revealed that tumour cells were
composed of syncytiotrophoblast and cytotrophoblast cells (H&E
stain; magnification, x100; scale bar, 100 µm). (C) Image of
syncytiotrophoblast cells with large, multinucleated cells with
sizeable, irregular nuclei (magnification, x200; scale bar 50 µm.
(D) Immunohistochemical staining of human chorionic gonadotropin,
revealed strong cytoplasmic staining of the syncitiotrophoblast
tumour cells (magnification, x200; scale bar 50 µm). H&E,
haematoxylin and eosin. |
This tumour was positive for HCG and pan-CK, and the
percentage of Ki67-positive tumour cells (Ki67 index) was ~60%
(data not shown). The other immune-markers, such as AFP, Vim,
CD117, OCT3/4 and CD30 were negative (data not shown), which
ultimately ruled out the possibility of mixed GCT. Final staging of
the tumour was T2N0M1a S2 staged III-B according to the American
Joint Committee of Cancer TNMS classification (14).
The patient then received chemotherapy with
etoposide and cisplatin (EP). Considering the high-volume of lung
metastases of the male patient, bleomycin was excluded due to its
pulmonary toxicity. HCG levels decreased continuously after each
cycle of chemotherapy (Fig. 3),
and the patient no longer complained of haemoptysis. However, after
two cycles of chemotherapy, a brain MRI revealed new malignant
lesions in the (Fig. 4A) left
frontal lobe, (Fig. 4D) left
ventricle and (Fig. 4G) left
occipital lobe. Meanwhile, chest CT showed that some lung lesions
had decreased in size, while others had increased in size (Fig. 5A, B, E and
F). Stereotactic body radiotherapy
(SBRT) of the intracranial lesions was then administered (a dose of
40 Gy delivered in 10 fractions) with concurrent chemotherapy of
the third cycle. As the patient suffered from severe bone marrow
suppression during chemotherapy, the male patient refused further
HDCT or ASCT after six cycles of EP therapy. Although the HCG
levels decreased continuously and most of the metastases decreased
in size, the treatment was suspended for 6 weeks. Although
immunotherapy was recommended, the patient demanded to return to
Tibet with oral medication for economic and physical reasons.
Comprehensive assessment was then arranged. Laboratory results of
the tumour markers showed that HCG was elevated to 572.9 U/l and
LDH was 195 U/l. The brain MRI showed stable encephalic lesions
with slight reduction in size (Fig.
4A-I). The chest CT revealed that most of the pulmonary lesions
were decreasing in size, while others were slightly increasing in
size (Fig. 5A-H). The patient
returned to Tibet with oral etoposide. Notably, 4 weeks later the
patient agreed to receive immunotherapy of sintilimab along with
oral etoposide. However, without therapeutic evaluation the
condition of the patient deteriorated 2 weeks later. The patient
developed respiratory failure accompanied by massive haemoptysis
and eventually succumbed 2 days later at home.
Discussion
Clinical characteristics
GCT is the dominant histology (95%) among all
patients with TC, developed from a non-invasive tumour type known
as germ cell neoplasia in situ (GCNIS) (14). The clinical classification of GCTs
comprises two subgroups: Seminomas and NSGCTs (4). When presenting with a combination of
both, mixed GCTs will be managed identically to NSGCTs (14). GCTs have a distinctive pathobiology
whereby they primarily originate from gonocytes which fail to
differentiate into spermatogonia. Seminomas are halted in the
initial differentiation stage, exhibiting greater resemblance to
gonocytes (15). By contrast,
NSGCTs are highly heterogeneous and exhibit differing degrees of
differentiation across various histological subtypes, including
both embryonal carcinomas, the extraembryonic-derived CC and yolk
sac tumours, and the most highly differentiated somatic-like
teratomas (15). Generally,
non-seminomas tend to be less common than seminomas, but frequently
demonstrate greater aggression.
Among all subtypes of NSGCTs, testicular CC is the
most aggressive neoplasm. It is composed of cytotrophoblast,
intermediate trophoblast, and syncytiotrophoblast cells, and is
capable of producing a high level of HCG hormone (2). Cytotrophoblasts are trophoblastic
stem cells while the syncytiotrophoblast is a more differentiated
cell. Typically, syncytiotrophoblast cells exhibit a plexiform
pattern, surrounded by predominantly mononucleated cytotrophoblast
cells situated near hemorrhagic foci. Nonetheless, particular
samples may contain a syncytiotrophoblast component that is
inconspicuous (16). While
testicular CC is typically found alongside other histopathologic
components in mixed GCTs (for example, seminoma, embryonal
carcinoma, yolk sac tumour, and teratoma), pure CC accounts for
<1% of testicular neoplasms (2).
Testicular GCTs tend to affect younger individuals
and occur in sites along the migratory pathways of germ cells
during embryo-fetal life (17).
Testicular CC, as a rare type of testicular GCTs, occurs most
commonly in young men between the ages of 20 and 39(6). A PubMed literature search found that
the oldest patient reported with testicular CC was 63 years old,
and there was a markedly limited number of patients >50 years
old (18). In the present study,
to the best of our knowledge, the oldest patient with testicular CC
ever reported in English publications, is presented. It is commonly
difficult to distinguish this tumour in its early stages from other
more frequent diseases in older individuals (18). Therefore, delaying diagnosis
contributes to a reduction in the effectiveness of treatment in
older individuals. Moreover, given that older patients experience
more side effects from treatment than young adults, adequate
antineoplastic treatment is often unattainable (19). Although it is unclear whether
ageing plays a critical role in the disease process, it may be
associated with a poorer prognosis.
Due to its rapid proliferation and vascular
invasion, testicular CC tends to exhibit hematogenous spread to the
lungs, liver, and brain at an early stage. Patients usually present
with symptoms related to metastases rather than a swelling mass in
the testis. Thus the clinical presentation of metastatic CC of the
testis is so varied that each case may be a diagnostic challenge
(12). Such patients usually
present with advanced metastatic disease due to a delay in the
diagnosis. Notably, ~30% of cases of testicular CC have metastatic
disease at the time of diagnosis. The lungs (80%) are the most
common site of metastasis, followed by the vagina (30%) and the
liver (10%) (11). Moreover, a
propensity for haemorrhage is well recognized in patients with
gestational trophoblastic disease, including those with testicular
CC. Haemorrhage was identified as the cause of death in 44% of the
patients diagnosed with testicular CC during autopsy (20). Therefore, it is commonly observed
that patients present with haemorrhage from metastatic sites.
Otherwise, high-volume pulmonary metastases can cause acute
impairments in breathing, resulting in fatal respiratory failure.
In recent years, there have been a few reported cases of
hyperthyroidism in patients with testicular CC. This could be
attributed to the structural similarity of HCG and
thyroid-stimulating hormone (TSH) (21).
Patients with advanced GCT could develop
choriocarcinoma syndrome (CS), which is characterized by rapid
hematologic spread of malignancy to multiple organs with
intratumoural bleeding (22). It
occurs more frequently in those with a high-volume of CC elements
and an HCG level over 50,000 IU/l. Typically, CS occurs shortly
after the administration of chemotherapy and is associated with
high morbidity and mortality (23).
Treatment. Standard treatment
Typically, radical orchiectomy should be performed
when clinically confirmed, allowing for proper diagnosis and
primary tumour control (14).
Prompt initiation of chemotherapy is also a well-known determinant
of prognosis of metastatic CC. Cisplatin-based regimens are
recommended for fist-line chemotherapy, including EP, bleomycin EP,
oretoposide, ifosfamide and cisplatin (VIP).
Patients with testicular CC should receive at least
four cycles of chemotherapy with ongoing monitoring of HCG
(12). Based on the risk of
developing CS or acute respiratory failure during chemotherapy, new
alternative approaches have been developed for patients with
advanced diseases in recent years. The effective approach is a
shortened or reduced course of induction chemotherapy prior to
administering the full-dose chemotherapeutic regimen (22). Furthermore, salvage treatments
should be considered for cases of refractory disease, in which HCG
levels plateau after several cycles. For those patients who relapse
or show resistance to first-line chemotherapy, combination salvage
chemotherapy is typically recommended, such as paclitaxel,
ifosfamide and cisplatin (TIP), gemcitabine and oxaliplatin
(GemOx), gemcitabine, oxaliplatin and paclitaxel (GOP), or
irinotecan combined with nedaplatin (19,24).
Additionally, HDCT with ASCT should be taken into consideration for
specific patients with resistant testicular CC (13,25).
Taza et al (26) found daily oral etoposide therapy
produced encouraging efficacy results in patients with relapsed
NSGCT who completed HDCT and peripheral-blood stem-cell transplant
(PBSCT) and achieved complete serologic remission and hematologic
recovery. Therefore, oral etoposide may be used as supplementary
treatment for patients who have already achieved complete
remission, but not as maintenance treatment for patients with large
amounts of residual tumour.
In the present case report, the patient presented
with massive pulmonary metastases and a high serum HCG level, which
are known to be associated with a poor prognosis (12). In order to avoid respiratory
failure and tumour lysis syndrome, EP therapy was administered
without bleomycin or ifosfamide after radical orchiectomy. The
serum HCG levels of the patient gradually decreased after each
cycle of chemotherapy, but remained elevated to normal levels after
six cycles of chemotherapy. The patient suffered from severe bone
marrow suppression throughout the chemotherapy, which was probably
due to the advanced age of the patient. Instead of HDCT with stem
cell rescue, the patient opted for oral chemotherapy, which
ultimately failed to control the disease.
Generally, testicular GCTs are malignant neoplasms
with excellent curative potential, even in advanced stages,
primarily attributed to the incorporation of cisplatin into
treatment protocols (27).
However, testicular CC is a unique type of GCT with a markedly
higher likelihood that patients may develop cisplatin-refractory or
progressive disease despite high-dose salvage chemotherapy
treatment. Failure to achieve complete tumour remission following
multiple salvage treatments is a definite indicator of poor
prognosis for this specific patient group (12).
Radiotherapy
The patient succumbed to rapidly progressing
pulmonary metastases, but the brain lesions remained stable after
radiotherapy until the patient succumbed. Historically, NSGCTs have
been considered relatively radioresistant compared with seminomas,
and radiotherapy is consequently excluded from curative strategies
(28). In order to control the
radioresistant disease, higher doses of radiation are required
which would probably lead to severe side effects. However, modern
techniques including stereotactic radiotherapy (SRT), which allows
very high dose delivery in small volumes, have rendered
radiotherapy applicable in multimodal treatments for NSGCTs.
Several clinical trials have investigated the potential of SRT in
NSGCTs, and the results appear to be encouraging (28,29).
The potential applications of SRT in NSGCTs would likely be in
areas of platinum-refractory disease and consolidation therapy for
residual masses after primary systemic therapy.
Targeted therapy
Treatment of patients with advanced testicular CC
has been a challenge for numerous years. It is particularly
difficult for patients with high serum levels of HCG and a high
volume of metastases, even after four cycles of chemotherapy
(19). For these patients,
additional cycles with a salvage regimen are warranted. In the case
of refractory or relapsed disease, advanced treatments such as HDCT
with ASCT should be considered (13). However, for patients ineligible or
resistant to such aggressive treatments, further investigation of
novel therapeutic agents is essential (30). In recent years, multiple studies
have investigated the role of targeted therapies in refractory GCTs
(30-34).
These new targeted agents may offer longer response durations with
fewer side effects, rendering maintenance therapy with improved
overall survival (OS) feasible for refractory GCTs.
Several receptor tyrosine kinases, including KIT,
ERBB2, PDGFR and VEGFR, have been implicated in the activation of
the MAPK and PI3K/AKT/mTOR pathways in TC (32). The PI3K/AKT/mTOR pathway has been
shown to inhibit tumour growth in in vitro and in
vivo TC models. But clinical therapeutic response to sunitinib,
pazopanib, imatinib, cabozantinib and everolimus has been limited
to case reports and a few small phase II clinical trials, with
objective response rates (ORRs) ranging from 0-20% (33,34).
The combination of targeted agents with cisplatin has been shown to
increase therapeutic efficacy in several preclinical studies
(35-37).
Therefore, these targeted therapies may not be recommended as
single-agent treatment. However, in all of these preclinical and
clinical studies, cases of testicular CC were extremely rare and no
significant antineoplastic activity was demonstrated in the rarest
subtype of TC (32-37).
Angiogenesis, the formation of new blood vessels
from vascular endothelium, is a key event in tumour development.
The vascular endothelial growth factor (VEGF) is currently
recognized as the major inducer of angiogenesis and vascular
permeability. VEGF receptors are almost exclusively expressed on
the surface of endothelial cells, but are overexpressed in GCTs
(38). Several clinical trials
have attempted to achieve satisfactory results with a combination
of chemotherapy and bevacizumab in refractory GCTs. Jain et
al (39) reported that
combination therapy with oxaliplatin and bevacizumab in patients
with refractory GCTs showed an ORR of 27.6% (8 out of 29 patients)
in a phase II clinical trial (39). However, the contribution of
bevacizumab to the effectiveness of the treatment cannot be
identified. Another trial treated 43 patients with GCTs with high
doses of bevacizumab in combination with chemotherapy (gemcitabine,
docetaxel and carboplatin). An ORR of 89% was achieved, but the
high rate of side effects rendered this regimen infeasible in some
patients (40). Further studies of
anti-angiogenic agents in GCTs, including CC, may shed light on
combination therapy and maintenance treatment.
A translational research study investigated the
expression of the poly (ADP-ribose) polymerase (PARP) pathway in
124 patients with GCTs. The expression rate of PARP in tumour
tissue reached high levels in varied subtypes, such as 100% in
intratubular germ cell neoplasia unclassified (IGCNU), 52.6% in
seminomas, 47% in embryonic carcinomas, 33.3% in yolk sac tumours,
26.7% in teratomas and 25% in CC (41). Patients with low PARP expression in
tumour tissue had improved overall survival (OS) than patients with
high PARP expression, but the difference was not statistically
significant (41). De Giorgi et
al (42) reported that
olaparib as a single agent showed no objective response in heavily
pretreated patients with GCT (n=18), with only 5 patients (27.8%)
achieving stable disease. Another clinical trial evaluated
veliparib in combination with gemcitabine and carboplatin (n=15),
also revealing limited efficacy with 4 partial remissions (26.7%)
and 5 cases of disease stabilization (33.3%) (43).
The CD30 cell surface protein is commonly expressed
in Hodgkin's lymphoma cells, anaplastic large cell lymphoma (ALCL)
cells and embryonal carcinomas. However it can also be found on
pure seminomas and seminomatous components of mixed GCTs (44,45).
Notably, patients with GTC and with CD30-expressing tumours had
worse progression-free survival (PFS) and OS compared with patients
with CD30-negative tumours. In addition, 56-60% of CD30-positive
GCTs would convert to CD30-negative during cisplatin-based
chemotherapy. The maintenance of CD30 expression is a marker of
poorer prognosis (46,47). Brentuximab vedotin is an anti-CD30
antibody linked to the antimitotic agent monomethyl auristatin E,
which is FDA-approved for the treatment of Hodgkin's lymphoma, ALCL
and cutaneous T-cell lymphoma. A phase II clinical trial enrolled 9
patients with CD30+ refractory GCT, of which 1 patient
achieved a complete response and 1 patient a partial response (ORR,
22.2%) (48). Both patients who
achieved therapeutic response had mixed GCTs with embryonal
carcinoma, and one of them had a CC component. In another study, 2
out of 5 CD30+ patients with relapsed or refractory GCTs
achieved an objective response [Partial response (PR), 1; and
complete response (CR), 1], and 2 patients had a CC component [PR,
1; and stable disease (SD), 1] (49).
Immunotherapy
Immunotherapies have reached important milestones
with clinical impact in recent years in numerous cancer models,
including TCs. There are two main studies investigating the role of
PD-L1 in the treatment of GCTs (50,51).
Both studies reported a higher expression of PD-L1 in tumour
compared with normal testicular tissue, and patients with low PD-L1
expression had significantly improved PFS and OS compared with
patients with high PD-L1.
High PD-L1 expression was detected in CC (52.6%),
embryonal carcinomas (12.5%), teratomas (9.1%) and seminomas (2.2%)
(51). Additionally, Lobo et
al (52) found that the tumour
cell intensity of cytotoxic T-lymphocyte-associated antigen 4 was
significantly higher in yolk sac tumours, teratomas and CC, while
PD-L1 tumour cell positivity was significantly more frequent in CC.
This is probably because CC is the only subtype of GCTs that
expresses PD-L1 in tumour cells, whereas other subtypes express
varying levels of PD-L1 primarily on tumour-associated macrophages
(53). Therefore, in contrast to
other subtypes of TC, PD-L1 may have more therapeutic potential in
CC. However, Kawahara et al (54) reported that in a phase II trial of
nivolumab monotherapy in chemo-refractory germ cell tumours, tumour
mutation burden (TMB) was a potential biomarker of therapeutic
response instead of PD-L1 expression. As the inclusion of
testicular CC in this study remained unclear, further investigation
into prognostic factors predicting response to immunotherapy in
testicular CC was warranted.
There were some case reports on the efficacy of
PD-1/PD-L1 blockade therapy in male patients with primary CC. Chi
and Schweizer (55) reported that
1 male patient with metastatic CC achieved a partial but durable
response to nivolumab treatment. However, Loh and Fung (56) reported that one patient with
testicular CC did not respond to pembrolizumab treatment and
progressed rapidly. Moreover, Han et al (57) reported that 1 patient with primary
neck CC whose PD-L1 expression was 40%, achieved complete remission
after pembrolizumab treatment combined with cytotoxic
chemotherapy.
Despite these case reports, there were several case
series or small phase II studies that have evaluated the
effectivity of immunotherapy in refractory and relapsed patients
with GCTs. Zschäbitz et al (58) reported that 3 out of 7 refractory
GCTs responded to anti-PD1 (nivolumad or pembrolizumab) treatment.
However, Adra et al (59)
reported that out of 12 patients with refractory NSGCTs, only 2
patients were PD-L1 positive (one of them was with predominant CC)
and did not respond to pembrolizumab. In another phase II study,
Tsimberidou et al reported that 12 patients with refractory
GCTs (10 men and 2 women) were treated with pembrolizumab. No
objective response was observed, but 3 patients remained
radiographically stable for 10.9, 5.5 and 4.5 months, respectively
(60). Moreover, another study
showed that avelumab was not effective in patients with multiple
relapsed/refractory non-seminomas (61). Kawahara et al (54) reported that out of 17 patients with
chemo-refractory GCTs treated with nivolumab, 1 patient achieved PR
with a median duration of 90.1 weeks and 3 patients achieved SD
with a median duration of 11.7 (range, 5.9-68.4) weeks. These
results suggest that only selected patients with GCTs may benefit
from immune checkpoint inhibitors as a potentially effective
treatment. The low mutational burden and low number of neoantigens
in TC tumours may contribute to the lack of clinical efficacy
(31). Meanwhile, several clinical
trials of PD-L1/PD1 combinations are underway, including nivolumab
in combination with ipilimumab, durvalumab in combination with
tremelimumab, nivolumab in combination with cabozantinib with or
without ipilimumab (62-65).
In conclusion, it is crucial to investigate prognostic factors that
predict response to immunotherapy. Furthermore, the combination of
different immunotherapy checkpoint inhibitors with cytotoxic
chemotherapy may lead to improved clinical outcomes.
All the aforementioned clinical trials of promising
targeted treatments are summarized in Table I. Although immunotherapy has shown
therapeutic potential for testicular CC in some studies, the
patient in the present case report did not achieve a therapeutic
response, which may be due to the extremely advanced stage of the
cancer. As immunotherapy has been shown to have a slow but
long-lasting effect, this patient may have benefitted more from
immunotherapy on the condition of earlier intervention. However, it
should be noted that only a few studies included a limited number
of patients with CC, due to its extremely low incidence. Therefore,
further investigations are warranted to evaluate the clinical
activity and therapeutic side effects of new targeted agents in
testicular GCTs, especially in testicular CC.
 | Table IClinical trials of promising targeted
therapies for GCTs. |
Table I
Clinical trials of promising targeted
therapies for GCTs.
| Target | Therapy | Trial phase | Main findings | Design | Status (Refs.) | NCT identifier | Histological
subtype: Including CC or not |
|---|
| VEGFR | Oxaliplatin +
bevacizumab | Phase II | OR 27.6% (CR, 1;
PR, 7; and SD, 1) | 29 pts of
relapsed/refractory GCTs (72.4% platinum-sensitive) | Completed (36) | | N/A |
| VEGFR | Bevacizumab +
ifosfamide high doses + carboplatin + etoposide | Phase II | OR 89% (PR, 15; CR,
4; and SD, 2), but high rate of side effects | 43 pts of
relapsed/refractory GCTs (14% platinum-sensitive) | Completed (37) | | N/A |
| PARP | Olaparib | Phase II | CR/PR, 0; and SD,
5 | 18 pts of
relapsed/refractory metastatic GCTs | Completed (39) | NCT02533765 | N/A |
| PARP + DNMT | Veliparib +
gemcitabine + carboplatin | Phase II | OR 26.7% (CR, 0;
PR, 4; and SD, 5) | 15 pts of
relapsed/refractory GCTs (80% platinum-sensitive) | Completed (40) | NCT02860819 | N/A |
| CD30 | Brentuximab
vedotin | Phase II | OR 22.2% (CR, 1;
PR, 1; and SD, 1) | 9 pts of
relapsed/refractory GCTs | Completed (45) | NCT01851200 | 1 PR: Mixed GCT
including CC |
| CD30 | Brentuximab
vedotin | Case series | CR, 1; PR, 1; and
SD, 1 | 5 pts of
relapsed/refractory GCTs (67% platinum-sensitive) | N/A (46) | | 1 PR and 1 SD:
Mixed GCTs including CC |
Other targeted agents
c-KIT is overexpressed in GCTs, predominantly in
seminomas, and nearly absent in CC and teratocarcinomas (66-68).
The c-KIT inhibitor, imatinib, has been demonstrated to be of low
clinical effectiveness in GCTs (69,70).
Therefore, c-KIT inhibitors should not be considered as therapeutic
agents for testicular CC.
Cyclin-dependent kinases 4 and 6 (CDK4/6) are
associated with cyclin D phosphorylate, Rb, which leads to cell
cycle progression. Teratomas have been shown to have significantly
higher expression levels of Rb protein than undifferentiated GCTs
(71). In addition, the CDK4/6
inhibitors have been demonstrated to be potentially beneficial for
teratomas in several clinical trials (72,73).
Further investigation of CDK4/6 inhibitors should be initiated for
the treatment of teratomas, but not for testicular CC.
Claudin 6 (CLDN6) is a tight junction membrane
protein, which was found to be overexpressed ubiquitously in all
elements of GCTs (74).
Preclinical data indicates that >90% (n=97/104) of TC tissue
samples with various histological components were positive for
CLDN6, including seminomas, embryonal carcinomas, yolk sac tumours,
CC, and teratomas (72). The
anti-CLDN6 monoclonal antibody ASP1650, also known as IMAB027, has
been shown to induce cell death as a single agent in preclinical
studies (75). However, in a phase
II clinical trial, ASP1650 did not appear to have clinically
meaningful single-agent activity in relapsed/refractory GCTs. A
change in CLDN6 expression over time and/or the mechanism of action
of ASP1650 may explain the lack of clinical activity (76). Therefore, further studies should
focus on investigating other means of targeting CLDN6 with agents
that have a different mechanism of action.
In conclusion, testicular CC is a rare subtype of
testicular neoplasms, exhibiting a very heterogeneous behaviour,
and is mainly aggressive with poor prognosis. Preoperative
diagnosis is infrequent, and its treatment relies mainly on radical
surgical resection and chemotherapy. Radiotherapy is now limited to
the occasional circumstance. In refractory or relapsed cases,
aggressive treatments such as HDCT with ASCT should be
considered.
Recently, new targeted therapies, including
immunotherapy, have shown potential benefit for selected GCTs.
These targeted treatments emphasized longer duration of response
and fewer side effects of therapy, which could enable long-term
survival in refractory disease. However, clinical trials of
targeted therapy for GCTs are limited, particularly for testicular
CC. Reasons include the low incidence rate, the fact that these
patients are heavily pre-treated and exhibit a poor prognosis. The
future of targeted therapy for GCTs lies in the appropriate
selection of patients with a certain molecular profile and in
identifying predictive response and targeted drug resistance
factors.
Acknowledgements
Not applicable.
Funding
Funding: No funding was received.
Availability of data and materials
All data generated or analysed during the present
study are available from the corresponding author upon reasonable
request.
Authors' contributions
NL, LLL, CHW and CRM contributed to acquisition,
analysis and interpretation of the patient data presented in this
case report. NL and CRM substantially contributed to the conception
and the design of the study. All authors have made critical
revisions. NL and CRM confirm the authenticity of all the raw data.
All authors read and approved the final manuscript.
Ethics approval and consent to
participate
A relative of the patient provided written informed
consent for participation.
Patient consent for publication
A relative of the patient provided written informed
consent for publication of the data in the present study.
Competing interests
The authors declare that they have no competing
interests.
References
|
1
|
Siegel RL, Miller KD, Fuchs HE and Jemal
A: Cancer statistics, 2022. CA Cancer J Clin. 72:7–33.
2022.PubMed/NCBI View Article : Google Scholar
|
|
2
|
Alvarado-Cabrero I, Hernández-Toriz N and
Paner GP: Clinicopathologic analysis of choriocarcinoma as a pure
or predominant component of germ cell tumor of the testis. Am J
Surg Pathol. 38:111–118. 2014.PubMed/NCBI View Article : Google Scholar
|
|
3
|
Smith ZL, Werntz RP and Eggener SE:
Testicular cancer: Epidemiology, diagnosis, and management. Med
Clin North Am. 102:251–264. 2018.PubMed/NCBI View Article : Google Scholar
|
|
4
|
Sesterhenn IA and Davis CJ Jr: Pathology
of germ cell tumors of the testis. Cancer Control. 11:374–387.
2004.PubMed/NCBI View Article : Google Scholar
|
|
5
|
Moch H, Amin MB, Berney DM, Compérat EM,
Gill AJ, Hartmann A, Menon S, Raspollini MR, Rubin MA, Srigley JR,
et al: The 2022 World Health Organization Classification of tumours
of the urinary system and male genital organs-part A: Renal,
penile, and testicular tumours. Eur Urol. 82:458–468.
2022.PubMed/NCBI View Article : Google Scholar
|
|
6
|
Humphrey PA: Choriocarcinoma of the
Testis. J Urol. 192:934–935. 2014.PubMed/NCBI View Article : Google Scholar
|
|
7
|
Pattillo RA: Gestational and
non-gestational trophoblastic neoplasms: New developments in DNA
analysis, metabolic function, diagnosis and treatment. Curr Opin
Obstet Gynecol. 5:486–489. 1993.PubMed/NCBI
|
|
8
|
Ikura Y, Inoue T, Tsukuda H, Yamamoto T,
Ueda M and Kobayashi Y: Primary choriocarcinoma and human chorionic
gonadotrophin-producing giant cell carcinoma of the lung: Are they
independent entities? Histopathology. 36:17–25. 2000.PubMed/NCBI View Article : Google Scholar
|
|
9
|
Verbeek W, Schulten HJ, Sperling M,
Tiesmeier J, Stoop H, Dinjens W, Looijenga L, Wörmann B, Füzesi L
and Donhuijsen K: Rectal adenocarcinoma with choriocarcinomatous
differentiation: Clinical and genetic aspects. Hum Pathol.
35:1427–1430. 2004.PubMed/NCBI View Article : Google Scholar
|
|
10
|
Ji YS and Park SH: Clinical experience of
male primary choriocarcinoma at the samsung medical center. Cancer
Res Treat. 53:874–880. 2021.PubMed/NCBI View Article : Google Scholar
|
|
11
|
Iczkowski KA: Germ cell neoplasms of the
testis: Update for 2022. Semin Diagn Pathol. 40:2–21.
2023.PubMed/NCBI View Article : Google Scholar
|
|
12
|
Reilley MJ and Pagliaro LC: Testicular
choriocarcinoma: A rare variant that requires a unique treatment
approach. Curr Oncol Rep. 17(2)2015.PubMed/NCBI View Article : Google Scholar
|
|
13
|
Pierantoni F, Maruzzo M, Bimbatti D,
Finotto S, Marino D, Galiano A, Basso U and Zagonel V: High dose
chemotherapy followed by autologous hematopoietic stem cell
transplantation for advanced germ cell tumors: State of the art and
a single-center experience. Crit Rev Oncol Hematol.
169(103568)2022.PubMed/NCBI View Article : Google Scholar
|
|
14
|
Goldberg H, Klaassen Z, Chandrasekar T,
Fleshner N, Hamilton RJ and Jewett MAS: Germ cell testicular
tumors-contemporary diagnosis, staging and management of localized
and advanced disease. Urology. 125:8–19. 2019.PubMed/NCBI View Article : Google Scholar
|
|
15
|
Lobo J, Costa AL, Vilela-Salgueiro B,
Rodrigues Â, Guimarães R, Cantante M, Lopes P, Antunes L, Jerónimo
C and Henrique R: Testicular germ cell tumors: Revisiting a series
in light of the new WHO classification and AJCC staging systems,
focusing on challenges for pathologists. Hum Pathol. 82:113–124.
2018.PubMed/NCBI View Article : Google Scholar
|
|
16
|
Malassiné A and Cronier L: Hormones and
human trophoblast differentiation: A review. Endocrine. 19:3–11.
2002.PubMed/NCBI View Article : Google Scholar
|
|
17
|
Nistal M, Paniagua R, González-Peramato P
and Reyes-Múgica M: Perspectives in pediatric pathology, chapter
25. Testicular and paratesticular tumors in the pediatric age
group. Pediatr Dev Pathol. 19:471–492. 2016.PubMed/NCBI View Article : Google Scholar
|
|
18
|
Ramon y Cajal S, Pinango L, Barat A,
Moldenhauer F and Oliva H: Metastatic pure choriocarcinoma of the
testis in an elderly man. J Urol. 137:516–519. 1987.PubMed/NCBI View Article : Google Scholar
|
|
19
|
Lavoie JM and Kollmannsberger CK: Current
management of disseminated germ cell tumors. Urol Clin North Am.
46:377–388. 2019.PubMed/NCBI View Article : Google Scholar
|
|
20
|
Johnson DE, Appelt G, Samuels ML and Luna
M: Metastases from testicular carcinoma. Study of 78 autopsied
cases. Urology. 8:234–239. 1976.PubMed/NCBI View Article : Google Scholar
|
|
21
|
Martínez-Gallegos JC and Ovalle-Zavala EA:
Thyroid storm associated with testicular choriocarcinoma. Eur J
Case Rep Intern Med. 7(001754)2020.PubMed/NCBI View Article : Google Scholar
|
|
22
|
Rejlekova K, Cursano MC, De Giorgi U and
Mego M: severe complications in testicular germ cell tumors: The
choriocarcinoma syndrome. Front Endocrinol (Lausanne).
10(218)2019.PubMed/NCBI View Article : Google Scholar
|
|
23
|
Rejlekova K, Kalavska K, Makovnik M,
Hapakova N, Chovanec M, De Angelis V, Obertova J, Palacka P,
Sycova-Mila Z, Mardiak J and Mego M: Factors associated with
choriocarcinoma syndrome development in poor-risk patients with
germ cell tumors. Front Oncol. 12(911879)2022.PubMed/NCBI View Article : Google Scholar
|
|
24
|
Hamilton RJ, Canil C, Shrem NS, Kuhathaas
K, Jiang MD, Chung P, North S, Czaykowski P, Hotte S, Winquist E,
et al: Canadian Urological Association consensus guideline:
Management of testicular germ cell cancer. Can Urol Assoc J.
16:155–173. 2022.PubMed/NCBI View Article : Google Scholar
|
|
25
|
Lorch A, Neubauer A, Hackenthal M, Dieing
A, Hartmann JT, Rick O, Bokemeyer C and Beyer J: High-dose
chemotherapy (HDCT) as second-salvage treatment in patients with
multiple relapsed or refractory germ-cell tumors. Ann Oncol.
21:820–825. 2010.PubMed/NCBI View Article : Google Scholar
|
|
26
|
Taza F, Abonour R, Zaid MA, Althouse SK,
Anouti B, Akel R, Hanna NH, Adra N and Einhorn LH: Maintenance oral
etoposide after high-dose chemotherapy (HDCT) for patients with
relapsed metastatic germ-cell tumors (mGCT). Clin Genitourin
Cancer. 21:213–220. 2023.PubMed/NCBI View Article : Google Scholar
|
|
27
|
Moul JW, Paulson DF, Dodge RK and Walther
PJ: Delay in diagnosis and survival in testicular cancer: Impact of
effective therapy and changes during 18 years. J Urol. 143:520–523.
1990.PubMed/NCBI View Article : Google Scholar
|
|
28
|
Kersh CR, Constable WC, Hahn SS, Spaulding
CA, Eisert DR, Jenrette JM, Marks RD and Grayson J: Primary
malignant extragonadal germ cell tumors. An analysis of the effect
of the effect of radiotherapy. Cancer. 65:2681–2685.
1990.PubMed/NCBI View Article : Google Scholar
|
|
29
|
Laflamme P, Doucet C, Sirois C, Kopek N
and Vanhuyse M: Stereotactic radiation therapy for residual
chemorefractory primary mediastinal non-seminomatous germ cell
tumor after surgical thoracotomy. Pract Radiat Oncol. 7:260–263.
2017.PubMed/NCBI View Article : Google Scholar
|
|
30
|
Orszaghova Z, Kalavska K, Mego M and
Chovanec M: Overcoming chemotherapy resistance in germ cell tumors.
Biomedicines. 10(972)2022.PubMed/NCBI View Article : Google Scholar
|
|
31
|
Kalavska K, Schmidtova S, Chovanec M and
Mego M: Immunotherapy in testicular germ cell tumors. Front Oncol.
10(573977)2020.PubMed/NCBI View Article : Google Scholar
|
|
32
|
Koster R, van Vugt MA, Timmer-Bosscha H,
Gietema JA and de Jong S: Unravelling mechanisms of cisplatin
sensitivity and resistance in testicular cancer. Expert Rev Mol
Med. 15(e12)2013.PubMed/NCBI View Article : Google Scholar
|
|
33
|
de Vries G, Rosas-Plaza X, van Vugt MATM,
Gietema JA and de Jong S: Testicular cancer: Determinants of
cisplatin sensitivity and novel therapeutic opportunities. Cancer
Treat Rev. 88(102054)2020.PubMed/NCBI View Article : Google Scholar
|
|
34
|
Galvez-Carvajal L, Sanchez-Munoz A,
Ribelles N, Saez M, Baena J, Ruiz S, Ithurbisquy C and Alba E:
Targeted treatment approaches in refractory germ cell tumors. Crit
Rev Oncol Hematol. 143:130–138. 2019.PubMed/NCBI View Article : Google Scholar
|
|
35
|
Rosas-Plaza X, de Vries G, Meersma GJ,
Suurmeijer AJH, Gietema JA, van Vugt MATM and de Jong S: Dual
mTORC1/2 inhibition sensitizes testicular cancer models to
cisplatin treatment. Mol Cancer Ther. 19:590–601. 2020.PubMed/NCBI View Article : Google Scholar
|
|
36
|
Koster R, di Pietro A, Timmer-Bosscha H,
Gibcus JH, van den Berg A, Suurmeijer AJ, Bischoff R, Gietema JA
and de Jong S: Cytoplasmic p21 expression levels determine
cisplatin resistance in human testicular cancer. J Clin Invest.
120:3594–3605. 2010.PubMed/NCBI View Article : Google Scholar
|
|
37
|
Juliachs M, Vidal A, Del Muro XG, Piulats
JM, Condom E, Casanovas O, Graupera M, Germà JR, Villanueva A and
Viñals F: Effectivity of pazopanib treatment in orthotopic models
of human testicular germ cell tumors. BMC Cancer.
13(382)2013.PubMed/NCBI View Article : Google Scholar
|
|
38
|
Fukuda S, Shirahama T, Imazono Y, Tsushima
T, Ohmori H, Kayajima T, Take S, Nishiyama K, Yonezawa S, Akiba S,
et al: Expression of vascular endothelial growth factor in patients
with testicular germ cell tumors as an indicator of metastatic
disease. Cancer. 85:1323–1330. 1999.PubMed/NCBI
|
|
39
|
Jain A, Brames MJ, Vaughn DJ and Einhorn
LH: Phase II clinical trial of oxaliplatin and bevacizumab in
refractory germ cell tumors. Am J Clin Oncol. 37:450–453.
2014.PubMed/NCBI View Article : Google Scholar
|
|
40
|
Nieto Y, Tu SM, Bassett R, Jones RB,
Gulbis AM, Tannir N, Kingham A, Ledesma C, Margolin K, Holmberg L,
et al: Bevacizumab/high-dose chemotherapy with autologous stem-cell
transplant for poor-risk relapsed or refractory germ-cell tumors.
Ann Oncol. 26:2507–2508. 2015.PubMed/NCBI View Article : Google Scholar
|
|
41
|
Mego M, Cierna Z, Svetlovska D, Macak D,
Machalekova K, Miskovska V, Chovanec M, Usakova V, Obertova J,
Babal P and Mardiak J: PARP expression in germ cell tumours. J Clin
Pathol. 66:607–612. 2013.PubMed/NCBI View Article : Google Scholar
|
|
42
|
De Giorgi U, Schepisi G, Gurioli G, Pisano
C, Basso U, Lolli C, Petracci E, Casadei C, Cecere SC, Attademo L,
et al: Olaparib as salvage treatment for advanced germ cell tumors
after chemotherapy failure: Results of the open-label, single-arm,
IGG-02 phase II trial. J Clin Oncol. 38 (15 suppl)(S5058)2020.
|
|
43
|
Mego M, Svetlovska D, Reckova M, Angelis
D, Kalavska K, Obertova J, Palacka P, Rejlekova K, Sycova-Mila Z,
Chovanec M and Mardiak J: Gemcitabine, carboplatin and veliparib in
multiple relapsed/refractory germ cell tumours: The GCT-SK-004
phase II trial. Invest New Drugs. 39:1664–1670. 2021.PubMed/NCBI View Article : Google Scholar
|
|
44
|
Hittmair A, Rogatsch H, Hobisch A, Mikuz G
and Feichtinger H: CD30 expression in seminoma. Hum Pathol.
27:1166–1171. 1996.PubMed/NCBI View Article : Google Scholar
|
|
45
|
Emerson RE and Ulbright TM: The use of
immunohistochemistry in the differential diagnosis of tumors of the
testis and paratestis. Semin Diagn Pathol. 22:33–50.
2005.PubMed/NCBI View Article : Google Scholar
|
|
46
|
Giannatempo P, Paolini B, Miceli R, Raggi
D, Nicolai N, Farè E, Catanzaro M, Biasoni D, Torelli T, Stagni S,
et al: Persistent CD30 expression by embryonal carcinoma in the
treatment time course: Prognostic significance of a worthwhile
target for personalized treatment. J Urol. 190:1919–1924.
2013.PubMed/NCBI View Article : Google Scholar
|
|
47
|
Berney DM, Shamash J, Pieroni K and Oliver
RT: Loss of CD30 expression in metastatic embryonal carcinoma: The
effects of chemotherapy? Histopathology. 39:382–385.
2001.PubMed/NCBI View Article : Google Scholar
|
|
48
|
Necchi A, Anichini A, Raggi D, Giannatempo
P, Magazzu D, Nicolai N, Colecchia M, Paolini B, Coradeschi E,
Tassi E, et al: Brentuximab vedotin in CD30-Expressing germ cell
tumors after chemotherapy failure. Clin Genitourin Cancer.
14:261–264 e4. 2016.PubMed/NCBI View Article : Google Scholar
|
|
49
|
Albany C, Einhorn L, Garbo L, Boyd T,
Josephson N and Feldman DR: Treatment of CD30-Expressing germ cell
tumors and sex cord stromal tumors with brentuximab vedotin:
Identification and report of seven cases. Oncologist. 23:316–323.
2018.PubMed/NCBI View Article : Google Scholar
|
|
50
|
Fankhauser CD, Curioni-Fontecedro A,
Allmann V, Beyer J, Tischler V, Sulser T, Moch H and Bode PK:
Frequent PD-L1 expression in testicular germ cell tumors. Br J
Cancer. 113:411–413. 2015.PubMed/NCBI View Article : Google Scholar
|
|
51
|
Cierna Z, Mego M, Miskovska V, Machalekova
K, Chovanec M, Svetlovska D, Hainova K, Rejlekova K, Macak D,
Spanik S, et al: Prognostic value of programmed-death-1 receptor
(PD-1) and its ligand 1 (PD-L1) in testicular germ cell tumors. Ann
Oncol. 27:300–305. 2016.PubMed/NCBI View Article : Google Scholar
|
|
52
|
Lobo J, Rodrigues Â, Guimarães R, Cantante
M, Lopes P, Maurício J, Oliveira J, Jerónimo C and Henrique R:
Detailed characterization of immune cell infiltrate and expression
of immune checkpoint molecules PD-L1/CTLA-4 and MMR proteins in
testicular germ cell tumors disclose novel disease biomarkers.
Cancers (Basel). 11(1535)2019.PubMed/NCBI View Article : Google Scholar
|
|
53
|
Sadigh S, Farahani SJ, Shah A, Vaughn D
and Lal P: Differences in PD-L1-Expressing macrophages and immune
microenvironment in testicular germ cell tumors. Am J Clin Pathol.
153:387–395. 2020.PubMed/NCBI View Article : Google Scholar
|
|
54
|
Kawahara T, Kawai K, Kojima T, Nagumo Y,
Sakka S, Kandori S, Negoro H, Mathis BJ, Maruo K, Miura K, et al:
Phase II trial of nivolumab monotherapy and biomarker screening in
patients with chemo-refractory germ cell tumors. Int J Urol.
29:741–747. 2022.PubMed/NCBI View Article : Google Scholar
|
|
55
|
Chi EA and Schweizer MT: Durable response
to immune checkpoint blockade in a platinum-refractory patient with
nonseminomatous germ cell tumor. Clin Genitourin Cancer.
15:e855–e857. 2017.PubMed/NCBI View Article : Google Scholar
|
|
56
|
Loh KP and Fung C: Novel therapies in
platinum-refractory metastatic germ cell tumor: A case report with
a focus on a PD-1 inhibitor. Rare Tumors. 9(6867)2017.PubMed/NCBI View Article : Google Scholar
|
|
57
|
Han C, Zhou Y, Ma JA, Liu J, Jiang YN and
Zhang HX: A promising treatment option for refractory male primary
choriocarcinoma: Report of two cases. Transl Cancer Res.
9:3054–3060. 2020.PubMed/NCBI View Article : Google Scholar
|
|
58
|
Zschabitz S, Lasitschka F, Hadaschik B,
Hofheinz RD, Jentsch-Ullrich K, Gruner M, Jager D and Grullich C:
Response to anti-programmed cell death protein-1 antibodies in men
treated for platinum refractory germ cell cancer relapsed after
high-dose chemotherapy and stem cell transplantation. Eur J Cancer.
76:1–7. 2017.PubMed/NCBI View Article : Google Scholar
|
|
59
|
Adra N, Einhorn LH, Althouse SK,
Ammakkanavar NR, Musapatika D, Albany C, Vaughn D and Hanna NH:
Phase II trial of pembrolizumab in patients with platinum
refractory germ-cell tumors: A Hoosier Cancer Research Network
Study GU14-206. Ann Oncol. 29:209–214. 2018.PubMed/NCBI View Article : Google Scholar
|
|
60
|
Tsimberidou AM, Vo HH, Subbiah V, Janku F,
Piha-Paul S, Yilmaz B, Gong J, Naqvi MF, Tu SM, Campbell M, et al:
Pembrolizumab in patients with advanced metastatic germ cell
tumors. Oncologist. 26:558–e1098. 2021.PubMed/NCBI View Article : Google Scholar
|
|
61
|
Mego M, Svetlovska D, Chovanec M, Rečkova
M, Rejlekova K, Obertova J, Palacka P, Sycova-Mila Z, De Giorgi U
and Mardiak J: Phase II study of avelumab in multiple
relapsed/refractory germ cell cancer. Invest New Drugs. 37:748–754.
2019.PubMed/NCBI View Article : Google Scholar
|
|
62
|
McGregor BA, Campbell MT, Xie W, Farah S,
Bilen MA, Schmidt AL, Sonpavde GP, Kilbridge KL, Choudhury AD,
Mortazavi A, et al: Results of a multicenter, phase 2 study of
nivolumab and ipilimumab for patients with advanced rare
genitourinary malignancies. Cancer. 127:840–849. 2021.PubMed/NCBI View Article : Google Scholar
|
|
63
|
Necchi A, Giannatempo P, Raggi D, Mariani
L, Colecchia M, Fare E, Monopoli F, Calareso G, Ali SM, Ross JS, et
al: An open-label randomized phase 2 study of durvalumab alone or
in combination with tremelimumab in patients with advanced germ
cell tumors (APACHE): Results from the first planned interim
analysis. Eur Urol. 75:201–203. 2019.PubMed/NCBI View Article : Google Scholar
|
|
64
|
National Library of Medicine (NIH):
Clinical Trials Database: NCT03158064. National Library of
Medicine, Bethesda, MD, 2023. https://www.clinicaltrials.gov/ct2/show/NCT03158064.
|
|
65
|
Apolo AB, Nadal R, Girardi DM, Niglio SA,
Ley L, Cordes LM, Steinberg SM, Sierra Ortiz O, Cadena J, Diaz C,
et al: Phase I study of cabozantinib and nivolumab alone or with
ipilimumab for advanced or metastatic urothelial carcinoma and
other genitourinary tumors. J Clin Oncol. 38:3672–3684.
2020.PubMed/NCBI View Article : Google Scholar
|
|
66
|
Nikolaou M, Valavanis C, Aravantinos G,
Fountzilas G, Tamvakis N, Lekka I, Arapantoni-Dadioti P, Zizi A,
Ghiconti I, Economopoulos T and Pectasides D: Kit expression in
male germ cell tumors. Anticancer Res. 27 (3B):1685–1688.
2007.PubMed/NCBI
|
|
67
|
Madani A, Kemmer K, Sweeney C, Corless C,
Ulbright T, Heinrich M and Einhorn L: Expression of KIT and
epidermal growth factor receptor in chemotherapy refractory
non-seminomatous germ-cell tumors. Ann Oncol. 14:873–880.
2003.PubMed/NCBI View Article : Google Scholar
|
|
68
|
Durán I, García-Velasco A, Ballestín C,
García E, Martínez-Tello F, Pond GR, García-Carbonero R,
Cortés-Funés H and Paz-Ares L: Expression of EGFR, HER-2/neu and
KIT in germ cell tumours. Clin Transl Oncol. 12:443–449.
2010.PubMed/NCBI View Article : Google Scholar
|
|
69
|
Einhorn LH, Brames MJ, Heinrich MC,
Corless CL and Madani A: Phase II study of imatinib mesylate in
chemotherapy refractory germ cell tumors expressing KIT. Am J Clin
Oncol. 29:12–13. 2006.PubMed/NCBI View Article : Google Scholar
|
|
70
|
Piulats J, Muro X, Huddart R, Aparicio J
and Sanchez M: Phase II multicenter study of imatinib in patients
with chemorefractory germ cell tumors that express c-kit. Cancer
Res. 67 (9 Suppl)(2648)2007.
|
|
71
|
Strohmeyer T, Reissmann P, Cordon-Cardo C,
Hartmann M, Ackermann R and Slamon D: Correlation between
retinoblastoma gene expression and differentiation in human
testicular tumors. Proc Natl Acad Sci USA. 88:6662–6666.
1991.PubMed/NCBI View Article : Google Scholar
|
|
72
|
Vaughn DJ, Hwang WT, Lal P, Rosen MA,
Gallagher M and O'Dwyer PJ: Phase 2 trial of the cyclin-dependent
kinase 4/6 inhibitor palbociclib in patients with retinoblastoma
protein-expressing germ cell tumors. Cancer. 121:1463–1468.
2015.PubMed/NCBI View Article : Google Scholar
|
|
73
|
Castellano DE, Quinn DI, Feldman DR,
Fizazi K, Garcia del Muro X, Gietema JA, Lauer RC, Ising ME, Aregay
M, Crystal AS and Vaughn DJ: A phase II study of ribociclib in men
with unresectable, incurable teratoma with recent progression. J
Clin Oncol. 37 (7 suppl)(S517)2019.
|
|
74
|
Türeci Ö, Kreuzberg M, Walter K, Wöll S,
Schmitt R, Mitnacht-Kraus R, Nakajo I, Yamada T and Sahin U: The
anti-claudin 6 antibody, IMAB027, induces antibody-dependent
cellular and complement-dependent cytotoxicity in claudin
6-expressing cancer cells. Cancer Res. 78 (13 suppl)(S882)2018.
|
|
75
|
Türeci Ö, Wagner M, Paret C, Kreuzberg MM,
Wöll S, Walter K, Häcker SC, Nakajo I, Yamada T and Sahin U:
Claudin 6 is a carcinoembryonic antigen with cancer stem cell
marker features. Cancer Res. 78 (13_suppl)(S1907)2018.
|
|
76
|
Adra N, Vaughn DJ, Einhorn LH, Hanna NH,
Funt SA, Rosales M, Arozullah A and Feldman DR: A phase II study
assessing the safety and efficacy of ASP1650 in male patients with
relapsed refractory germ cell tumors. Invest New Drugs.
40:1087–1094. 2022.PubMed/NCBI View Article : Google Scholar
|